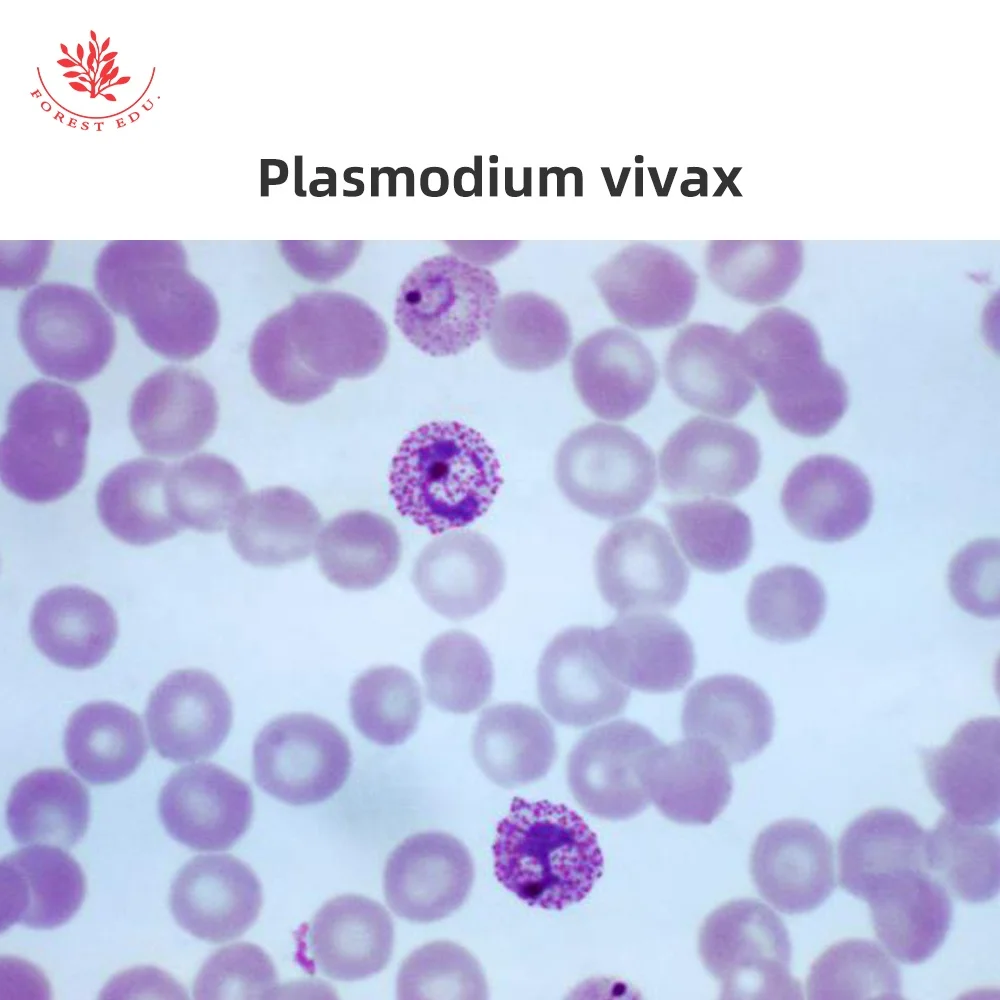
Microscope Slides 10Pcs Protozoa And Algae Slides Set Medical Science Microbiology Education Specimen Prepared Microscope Slides

Microscope Slides 10Pcs Protozoa And Algae Slides Set Medical Science Microbiology Education Specimen Prepared Microscope Slides
- Category: >>>
- Supplier: Xinxiang Red Forest Edu. Instrument Co. Ltd.
Share on (1600599249334):
Product Overview
Description
Product Description
Microscope Slides 10 Pcs Protozoa And Algae Slides Set Medical Science Microbiology Education Specimen Prepared Microscope Slides
We have exported medical products to many countries, please click here to view our transaction history :

Product Name | 10 Pcs Protozoa And Algae Slides Set |
Material | Clear glass - not fragile |
Function | School / hospital / clinic / laboratory / other etc |
Size | Microscope Slides size: 25.4mm*76.2mm* (1-2) mm / 1" x 3 " |
ITEM :
2.Vorticella
3.Paramecium
4.Euglena
5.Rotifer
1.Amoeba proteus
2.Vorticella
3.Paramecium
4.Euglena
5.Rotifer
6.Plasmodium vivax
7.Chlamydomonas
8.Diatom
9.Volvox
10.Desmids
Product Usage
The advantages of our prepared slides



Related Products
Packing&Shipping
PAYMENT

SHIPPING

Packaging & Factory




Company Introduction
Xinxiang Red Forest Edu. Instrument Co., Ltd.
successfulexperience,with a clear positioning and winning strategy. Qualified and experienced backbone force; Have
adynamic,innovative,enterprising,close cooperation team .24 hours service team online service We have a professional sales teamandR & Ddepartment, factorydirect sales, fast delivery cycle.



Why Choose Us
Our Services & Strength
ForestEdu employees consider our company to be a symbol of victory and success. We consider every customer to be the mo stimportant. We think we have quality products and services. As a young and enthusiastic team, we will strive to fulfill your needsand requirements. With a large inventory in our factory, we can cope with large and urgent orders quickly at competitive prices.We are in a strong position to meet your needs.
FAQ
1.Can we(I) buy online ?
Yes you can buy it directly on alibaba by Tradeassurance.
2.Is my money safe if I buy from online?
Of course, Alibaba is the biggest B2B website in China, it take strictly measures to guarantee buyers interests,
if you get the wrong products or bad quality products not as descriped,you could claim.
3.May I know the MOQ ?
1 piece per item, and you could mix different items for your convenience. And some product you can not make order directly fromthe website please ask our service people
4.I'm a personal buyer,do you support small order with many items?
Yes ,we do,no problem
5.Could you give me better price?
We would like to give you our best price generally ,and we have promotion usually.
6. Will my money be refunded if you sent is not I want?
OK, we would like to refund if you show the evidence to proof that it was caused by our faults.
7. What's the courier you often use to deliver the small parcels ?
We use EMS or DHL to ship the goods to you usually when the quantity is not big.
Yes you can buy it directly on alibaba by Tradeassurance.
2.Is my money safe if I buy from online?
Of course, Alibaba is the biggest B2B website in China, it take strictly measures to guarantee buyers interests,
if you get the wrong products or bad quality products not as descriped,you could claim.
3.May I know the MOQ ?
1 piece per item, and you could mix different items for your convenience. And some product you can not make order directly fromthe website please ask our service people
4.I'm a personal buyer,do you support small order with many items?
Yes ,we do,no problem
5.Could you give me better price?
We would like to give you our best price generally ,and we have promotion usually.
6. Will my money be refunded if you sent is not I want?
OK, we would like to refund if you show the evidence to proof that it was caused by our faults.
7. What's the courier you often use to deliver the small parcels ?
We use EMS or DHL to ship the goods to you usually when the quantity is not big.
Contact Us
Ms Amy
Mobile:037318237336978
Wechat:18237336978 Email:Amyforestedu@hotmail.com
Address:Xinxiang Red ForestEdu.Instrument Co.,Ltd.Manufacturer Trading Company
Mobile:037318237336978
Wechat:18237336978 Email:Amyforestedu@hotmail.com
Address:Xinxiang Red ForestEdu.Instrument Co.,Ltd.Manufacturer Trading Company

We Recommend
New Arrivals
New products from manufacturers at wholesale prices